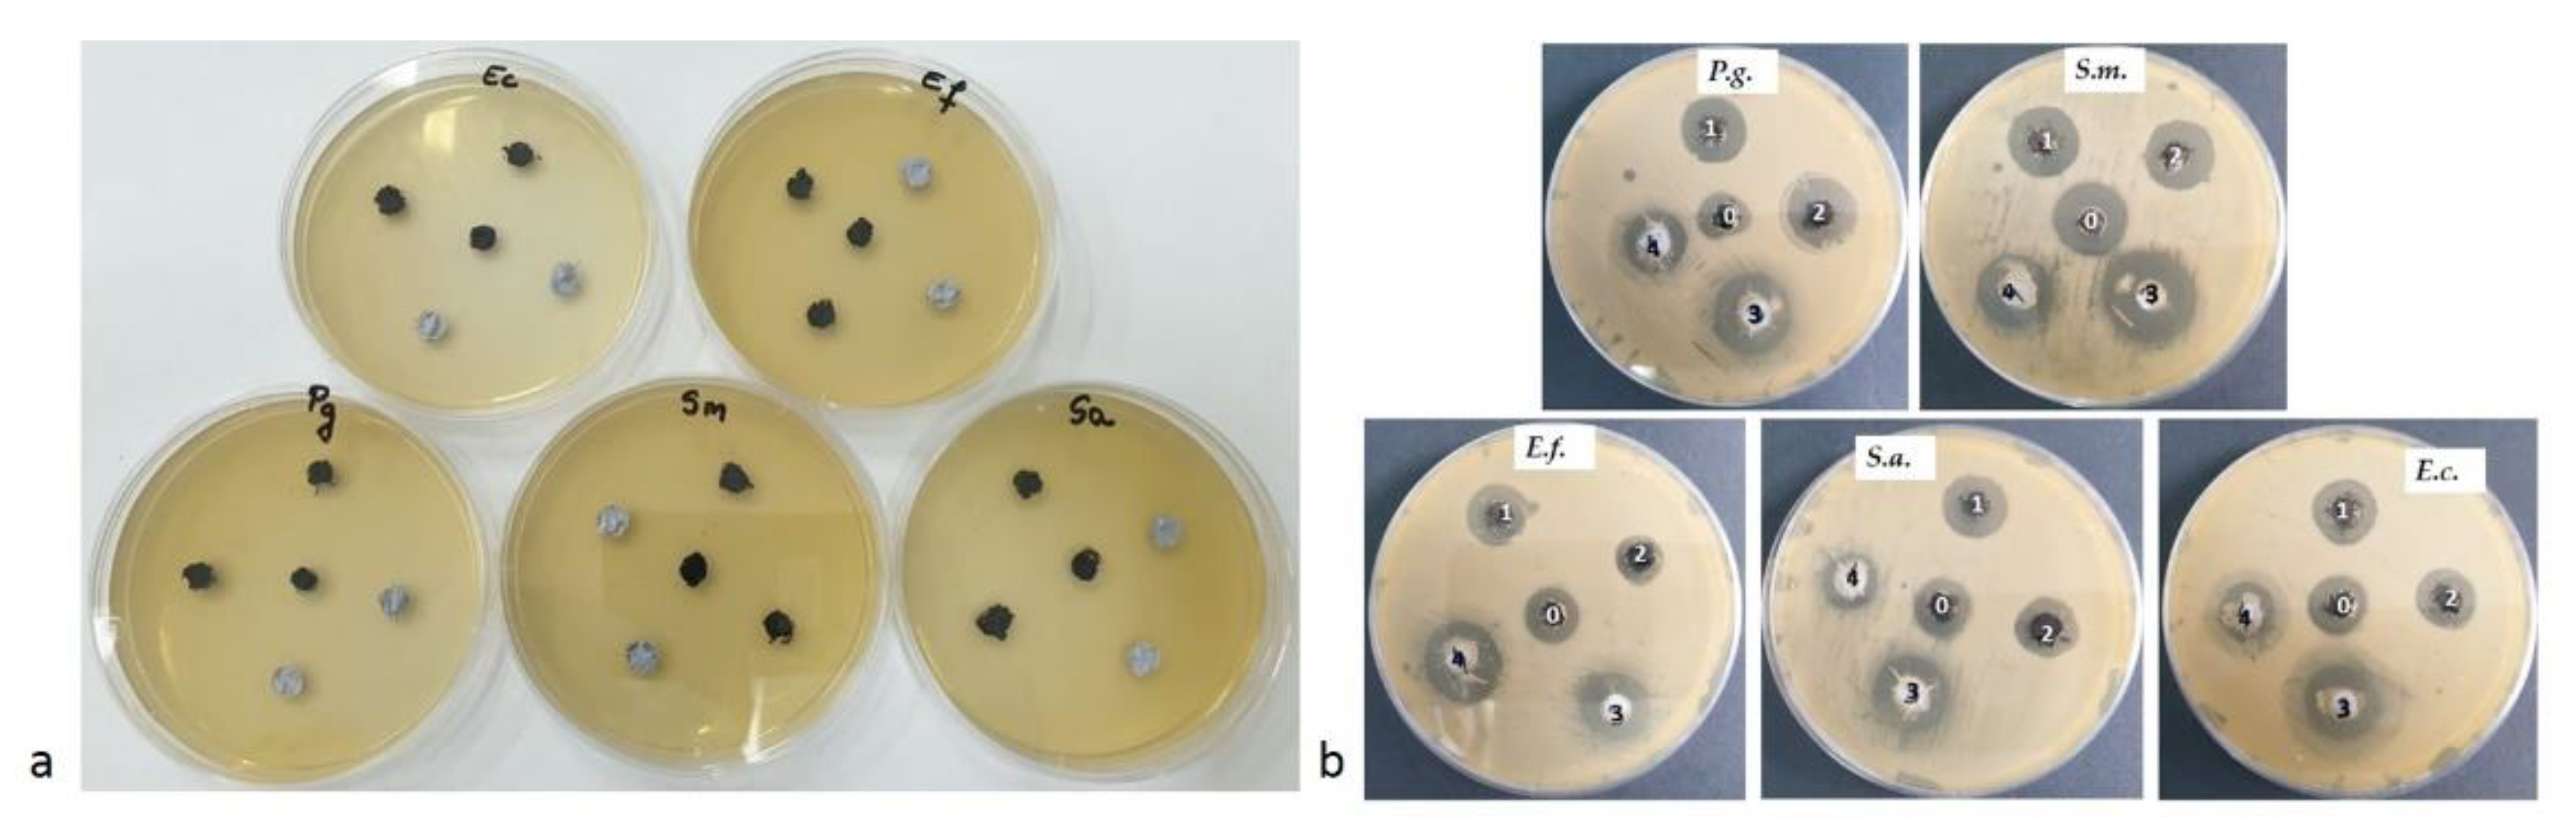
Applsci 11 11330 g008

Synthesis and Characterization of Some Graphene Oxide Powders Used as Additives in Hydraulic Mortars
Abstract
:1. Introduction
2. Materials and Methods
2.1. Materials
2.1.1. Synthesis of Graphene GO, GO-Ag and GO-ZnO Powders
Synthesis of Graphene Oxide
Synthesis of Ag Nanoparticles
Synthesis of GO-Ag Powder
Synthesis of GO-ZnO Nanopowder
2.1.2. Silanization of GO, GO-Ag and GO-ZnO Powders
2.2. Characterization Techniques
2.2.1. Fourier Transform Infrared Spectrometry (FT-IR)
2.2.2. Thermogravimetric Analysis (TG/DTA)
2.2.3. Ultraviolet–Visible Spectroscopy (UV-Vis)
2.2.4. Scanning Electron Microscopy (SEM)
2.2.5. Antibacterial Analysis
3. Results and Discussions
3.1. Fourier Transform Infrared Spectrometry (FT-IR)
3.2. Thermogravimetric Analysis (TG/DTA)
3.3. Ultraviolet–Visible Spectroscopy (UV-Vis)
3.4. Scanning Electron Microscopy (SEM)
3.5. Antibacterial Analysis
4. Conclusions
Author Contributions
Funding
Acknowledgments
Conflicts of Interest
References
- Popa, D.; Varvara, S.; Moldovan, M.; Prodan, D.; Carpa, R.; Varsta, A.; Popa, M. Study on the importance of physicochemical characteristics from the walls in the rehabilitation works of heritage buildings. J. Environ. Prot. Ecol. 2018, 19, 1166–1174. [Google Scholar]
- Faria, P.; Duarte, P.; Barbosa, D.; Ferreira, I. New composite of natural hydraulic lime mortar with graphene oxide. Constr. Build. Mater. 2017, 156, 1150–1157. [Google Scholar] [CrossRef] [Green Version]
- Sun, M.; Li, J. Graphene oxide membranes: Functional structures, preparation and environmental applications. Nano Today. 2018, 20, 121–137. [Google Scholar] [CrossRef]
- Han, S.; Sun, J.; He, S.; Tang, M.; Chai, R. The application of graphene-based biomaterials in biomedicine. Am. J. Transl. Res. 2019, 11, 3246–3260. [Google Scholar]
- Mkhoyan, K.A.; Contryman, A.W.; Silcox, J.; Stewart, D.A.; Eda, G.; Mattevi, C.; Miller, S.; Chhowalla, M. Atomic and electronic structure of graphene-oxide. Nano Lett. 2009, 9, 1058–1063. [Google Scholar] [CrossRef] [PubMed] [Green Version]
- Kumari, S.; Sharma, P.; Yadav, S.; Kumar, J.; Vij, A.; Rawat, P.; Kumar, S.; Sinha, C.; Bhattacharya, J.; Srivastava, C.M.; et al. A novel synthesis of the graphene oxide-silver (GO-Ag) nanocomposite for unique physiochemical applications. ACS Omega 2020, 5, 5041–5047. [Google Scholar] [CrossRef] [PubMed] [Green Version]
- Allahbakhsh, A.; Haghighi, A.H.; Sheydaei, M. Poly(ethylene trisulfide)/graphene oxide nanocomposites. J. Therm. Anal. Calorim. 2017, 128, 427–442. [Google Scholar] [CrossRef]
- Justh, N.; Berke, B.; László, K.; Szilágyi, I.M. Thermal analysis of the improved Hummers’ synthesis of graphene oxide. J. Therm. Anal. Calorim. 2018, 131, 2267–2272. [Google Scholar] [CrossRef] [Green Version]
- Lee, C.Y.; Bae, J.H.; Kim, T.Y.; Chang, S.H.; Kim, S.Y. Using silane-functionalized graphene oxides for enhancing the interfacial bonding strength of carbon/epoxy composites. Compos. A Appl. Sci. Manuf. 2015, 75, 11–17. [Google Scholar] [CrossRef]
- Vuppaladadiuma, S.S.R.; Agarwalb, T.; Kulanthaivela, S.; Mohantyc, B.; Barikc, C.S.; Maitib, T.K.; Pald, S.; Pala, K.; Banerjeea, I. Silanization improves biocompatibility of graphene oxide. Mater. Sci. Eng. C 2020, 110, 110647. [Google Scholar] [CrossRef] [PubMed]
- El-Shafai, N.; El-Khouly, M.E.; El-Kemary, M.; Ramadan, M.; Eldesoukey, I.; Masoud, M. Graphene oxide decorated with zinc oxide nanoflower, silver and titanium dioxide nanoparticles: Fabrication, characterization, DNA interaction, and antibacterial activity. RSC Adv. 2019, 9, 3704–3714. [Google Scholar] [CrossRef] [Green Version]
- Popa, D.; Carpa, R.; Moldovan, M.; Prodan, D.; Varvara, S.; Golumbeanu, M.; Popa, M. Culturable bacterial communities from the, spoiled walls of the heritage buildings. J. Environ. Prot. Ecol. 2019, 20, 773–780. [Google Scholar]
- Carpa, R.; Drăgan-Bularda, M.; Muntean, V. Microbiologie Generală: Lucrări Practice; Presa Universitară Clujeană: Cluj-Napoca, Romania, 2014. (In Romanian) [Google Scholar]
- Leaper, S.; Abdel-Karim, A.; Faki, B.; Luque-Alled, J.M.; Alberto, M.; Vijayaraghavan, A.; Holmes, S.M.; Szekely, G.; Badawy, M.I.; Shokri, N.; et al. Flux-enhanced PVDF mixed matrix membranes incorporating APTS-functionalized graphene oxide for membrane distillation. J. Membr. Sci. 2018, 554, 309–323. [Google Scholar] [CrossRef]
- Smith, B.C. Infrared interpretation. In A Systematic Approach; CRC Press: Boca Raton, FL, USA; London, UK; New York, NY, USA; Washington, DC, USA, 1999. [Google Scholar]
- Lucia, A.; Bacher, M.; van Herwijnen, H.W.; Rosenau, T. A direct silanization protocol for dialdehyde cellulose. Molecules 2020, 25, 2458. [Google Scholar] [CrossRef]
- Oh, T.; Choi, C.K. Comparison between SiOC thin films fabricated by using plasma enhance chemical vapor deposition and SiO2 thin films by using fourier transform infrared spectroscopy. J. Korean Phys. 2010, 56, 1150–1155. [Google Scholar] [CrossRef]
- Lewandowska, K.; Rosiak, N.; Bogucki, A.; CieleckaPiontek, J. Tuning Electronic and Magnetic Properties in Graphene Oxide–Porphyrins Complexes. OSF Prepr. 2019. [Google Scholar] [CrossRef]
- Habte, A.T.; Ayele, D.W. Synthesis and characterization of reduced graphene oxide (rGO) started from graphene oxide (GO) using the tour method with different parameters. Adv. Mater. Sci. Eng. 2019, 2019, 5058163. [Google Scholar] [CrossRef] [Green Version]
- da Silva, C.T.; Monteiro, J.P.; Radovanovic, E.; Girotto, E.M. Unprecedented high plasmonic sensitivity of substrates based on gold nanoparticles. Sens. Actuators B Chem. 2014, 191, 152–157. [Google Scholar] [CrossRef]
- Alruwais, R.S.; Adeosun, W.A.; Marwani, H.M.; Jawaid, M.; Asiri, A.M.; Khan, A. Novel aminosilane (APTES)-grafted polyaniline@ graphene oxide (PANI-GO) nanocomposite for electrochemical sensor. Polymers 2021, 13, 2562. [Google Scholar] [CrossRef]
- Aliyev, E.; Filiz, V.; Khan, M.M.; Lee, Y.J.; Abetz, C.; Abetz, V. Structural characterization of graphene oxide: Surface functional groups and fractionated oxidative debris. Nanomaterials 2019, 9, 1180. [Google Scholar] [CrossRef] [Green Version]
- Cham Sa-Ard, W.; Fawcett, D.; Fung, C.C.; Chapman, P.; Rattan, S.; Poinern, G.E.J. Synthesis, characterisation and thermo-physical properties of highly stable graphene oxide-based aqueous nanofluids for potential low-temperature direct absorption solar applications. Sci. Rep. 2021, 11, 16549. [Google Scholar] [CrossRef]
- Steiner, P. Nanoscopic Infrared Characterisation of Graphene Oxide. Doctoral Dissertation, University of Manchester, Manchester, UK, 2018; 94p. [Google Scholar]
- Balaji, A.; Yang, S.; Wang, J.; Zhang, J. Graphene oxide-based nanostructured DNA sensor. Biosensors 2019, 9, 74. [Google Scholar] [CrossRef] [Green Version]
- Batra, K.; Nayak, S.; Behura, S.K.; Jani, O. Optimizing performance parameters of chemically-derived graphene/p-Si heterojunc-tion solar cell. J. Nanosci. Nanotechnol. 2015, 15, 4877–4882. [Google Scholar] [CrossRef]
- Liu, P.; Yao, Z.; Zhou, J. Controllable synthesis and enhanced microwave absorption properties of silane-modified Ni 0.4 Zn 0.4 Co 0.2 Fe2O4 nanocomposites covered with reduced graphene oxide. RSC Adv. 2015, 5, 93739–93748. [Google Scholar] [CrossRef]
- Hanifah, M.F.; Jaafar, J.; Aziz, M.; Ismail, A.F.; Rahman, M.A.; Othman, M.H. Synthesis of graphene oxide nanosheets via modified hummers’ method and its physicochemical properties. J. Teknol. 2015, 74, 195–198. [Google Scholar] [CrossRef] [Green Version]
- Stroe, M.; Cristea, M.; Matei, E.; Galatanu, A.; Cotet, L.C.; Pop, L.C.; Baia, M.; Danciu, V.; Anghel, I.; Baia, L.; et al. Optical properties of composites based on graphene oxide and polystyrene. Molecules 2020, 25, 2419. [Google Scholar] [CrossRef]
- Weigel, C.; Kellner, R. FTIR-ATR-spectroscopic investigation of the silanization of germanium surfaces with 3-aminopropyltriethoxysilane. Fresenius Z. Anal. Chem. 1989, 335, 663–668. [Google Scholar] [CrossRef]
- Arkles, B.C.; Peterson, W.R., Jr.; Anderson, R. Silicon Compounds: Register and Review, 3rd ed.; Petrarch Systems Inc.: Bristol, PA, USA, 1984; 240p. [Google Scholar]
- Banu, R.; Salvi, N.; Ameta, C.; Ameta, R.; Punjabi, P.B. Visible light driven photocatalytic degradation of brilliant green dye using graphene oxide/copper oxide binary composite. Indian J. Chem. 2019, 58B, 157–166. [Google Scholar]
- Moura, I.A.D.B.; Sousa, T.G.D.; Lima, A.M.; Silva, W.O.D.; Brandao, L.P. Synthesis and characterization of graphene-oxide reinforced copper matrix composite. Mater. Proc. 2020, 4, 72. [Google Scholar] [CrossRef]
- Cahyana, A.H.; Liandi, A.R.; Yunarti, R.T.; Febriantini, D.; Ardiansah, B. Green synthesis of dihydropyrimidine based on cinnamaldehyde compound under solvent-free using graphene oxide as catalyst. AIP Conf. Proc. 2019, 2168, 020069. [Google Scholar] [CrossRef]
- Lozovskis, P.; Jankauskaitė, V.; Guobienė, A.; Kareivienė, V.; Vitkauskienė, A. Effect of graphene oxide and silver nanoparticles hybrid composite on P. aeruginosa strains with acquired resistance genes. Int. J. Nanomed. 2020, 15, 5147. [Google Scholar] [CrossRef] [PubMed]
- Li, N.; Chen, X.; Chen, X.; Ding, X.; Zhao, X. Ultrahigh humidity sensitivity of graphene oxide combined with Ag nanoparticles. RSC Adv. 2017, 7, 45988–45996. [Google Scholar] [CrossRef] [Green Version]
- Dai, J.; Zhao, H.; Ye, Y.; Wang, L.; Cao, S.; Su, X.; Hu, X.; Li, L. Improving the selectivity of magnetic graphene oxide through amino modification. Water Sci. Technol. 2017, 76, 2959–2967. [Google Scholar] [CrossRef] [Green Version]
- Yuan, H.; Qi, F.; Zhao, N.; Wan, P.; Zhang, B.; Xiong, H.; Liao, B.; Ouyang, X. Graphene oxide decorated with titanium nanoparti-cles to reinforce the anti-corrosion performance of epoxy coating. Coatings 2020, 10, 129. [Google Scholar] [CrossRef] [Green Version]
- Shaari, H.A.H.; Ramli, M.M.; Mohtar, M.N.; Razali, N.H.F. Characterization and conductivity of graphene oxide (GO) dispersion in different solvents. AIP Conf. Proc. 2021, 2332, 060001. [Google Scholar] [CrossRef]
- Xiong, G.; Pal, U.; Serrano, J.G.; Ucer, K.B.; Williams, R.T. Photoluminesence and FTIR study of ZnO nanoparticles: The impurity and defect perspective. Phys. Stat. Sol. 2006, 3, 3577–3581. [Google Scholar] [CrossRef]
- Saranya, M.; Ramachandran, R.; Wang, F. Graphene-zinc oxide (G-ZnO) nanocomposite for electrochemical supercapacitor applications. J. Sci. Adv. Mater. Devices. 2016, 1, 454–460. [Google Scholar] [CrossRef] [Green Version]
- Clarina, T.; Rama, V. [3 + 2] Cycloaddition promoted by zinc oxide nanoparticles anchored on reduced graphene oxide using green solvent. Synth. Commun. 2018, 48, 175–187. [Google Scholar] [CrossRef]
- Sookhakian, M.; Ridwan, N.A.; Zalnezhad, E.; Yoon, G.H.; Azarang, M.; Mahmoudian, M.R.; Alias, Y. Layer-by-layer electrodeposited reduced graphene oxide-copper nanopolyhedra films as efficient platinum-free counter electrodes in high efficiency dye-sensitized solar cells. J. Electrochem. Soc. 2016, 163, D154–D159. [Google Scholar] [CrossRef]
- Pang, Y.L.; Tee, S.F.; Lim, S.; Abdullah, A.Z.; Ong, H.C.; Wu, C.H.; Chong, W.C.; Mohammad, A.W.; Mahmoudi, E. Enhancement of photocatalytic degradation of organic dyes using ZnO decorated on reduced graphene oxide (rGO). Desalination Water Treat. 2018, 108, 311–321. [Google Scholar] [CrossRef]
- Xu, J.; Zhang, Y.; Gutha, Y.; Zhang, W. Antibacterial property and biocompatibility of chitosan/poly(vinyl alcohol)/ZnO (CS/PVA/ZnO) beads as an efficient adsorbent for Cu(II) removal from aqueous solution. Colloids Surf. B Biointerfaces 2017, 156, 340–348. [Google Scholar] [CrossRef]
- Soltani, T.; Lee, B.K. A benign ultrasonic route to reduced graphene oxide from pristine graphite. J. Colloid Interface Sci. 2017, 486, 337–343. [Google Scholar] [CrossRef]
- Eigler, S.; Dotzer, C.; Hof, F.; Bauer, W.; Hirsch, A. Sulfur species in graphene oxide. Chem. Eur. J. 2013, 19, 9490–9496. [Google Scholar] [CrossRef]
- Yang, H.; Li, F.; Shan, C.; Han, D.; Zhang, Q.; Niu, L.; Ivask, A. Covalent functionalization of chemically converted graphene sheets via silane and its reinforcement. J. Mater. Chem. 2009, 19, 4632–4638. [Google Scholar] [CrossRef]
- Zhang, X.; Zhang, W.; Li, Y.; Li, C. Hybrid luminescent materials of graphene oxide and rare-earth complexes with stronger luminescence intensity and better thermal stability. Dye. Pigment. 2017, 140, 150–156. [Google Scholar] [CrossRef]
- De Faria, A.F.; Martinez, D.S.T.; Meira, S.M.M.; de Moraes, A.C.M.; Brandelli, A.; Souza Filho, A.G.; Alves, O.L. Anti-adhesion and antibacterial activity of silver nanoparticles supported on graphene oxide sheets. Colloids Surf. B Biointerfaces 2014, 113, 115–124. [Google Scholar] [CrossRef]
- Yang, S.Q.; Yuan, P.; He, H.P.; Qin, Z.H.; Zhou, Q.; Zhu, J.X.; Liu, D. Effect of reaction temperature on grafting of γ-aminopropyl triethoxysilane (APTES) onto kaolinite. Appl. Clay Sci. 2012, 62, 8–14. [Google Scholar] [CrossRef]
- Li, D.; Müller, M.B.; Gilje, S.; Kaner, R.B.; Wallace, G.G. Processable aqueous dispersions of graphene nanosheets. Nat. Nanotechnol. 2008, 3, 101–105. Available online: http://www.nature.com/doifinder/10.1038/nnano.2007.451. (accessed on 4 October 2021). [CrossRef]
- Hidayah, N.M.S.; Liu, W.W.; Lai, C.W.; Noriman, N.Z.; Khe, C.S.; Hashim, U.; Lee, H.C. Comparison on graphite, graphene oxide and reduced graphene oxide: Synthesis and characterization. AIP Conf. Proc. 2017, 1892, 150002. [Google Scholar] [CrossRef]
- Emiru, T.F.; Ayele, D.W. Controlled synthesis, characterization and reduction of graphene oxide: A convenient method for large scale production. Egypt. J. Basic Appl. Sci. 2017, 4, 74–79. [Google Scholar] [CrossRef] [Green Version]
- Patil, A.G.; Bafna, H.R.; More, M.P.; Deshmukh, P.K.; Patil, P.O. Green Synthesis of graphene based silver nanocomposite for enhanced antibacterial activity against dental pathogens. JSM Nanotechnol. Nanomed. 2017, 5, 1058. [Google Scholar]
- Yang, Y.; Liu, T. Fabrication and characterization of graphene oxide/zinc oxide nanorods hybrid. Appl. Surf. Sci. 2011, 257, 8950–8954. [Google Scholar] [CrossRef]
- Singh, D.K.; Pandey, D.K.; Yadav, R.R.; Singh, D. A study of nanosized zinc oxide and its nanofluid. Pramana 2012, 78, 759–766. [Google Scholar] [CrossRef]
- Liu, S.; Zeng, T.H.; Hofman, M.; Burcombe, E.; Wei, J.; Jiang, R.; Kong, J.; Chen, Y. Antibacterial activity of graphite, graphene oxide, and reduced graphene oxide: Membrane and oxidative stress. ACS Nano 2011, 5, 6971–6980. [Google Scholar] [CrossRef]
- Moldovan, M.; Prodan, D.; Sarosi, C.; Carpa, R.; Socaci, C.; Rosu, M.C.; Pruneanu, S. Synthesis, morpho-structural properties and antibacterial effect of silicate-based composites containing graphene oxide/hydroxyapatite. Mater. Chem. Phys. 2018, 217, 48–53. [Google Scholar] [CrossRef]
- Ruiz, O.N.; Fernando, K.A.; Wang, B.; Brown, N.A.; Luo, P.G.; McNamara, N.D.; Vangsness, M.; Sun, Y.P.; Bunker, C.E. Graphene oxide: A nonspecific enhacer of cellular growth. ACS Nano 2011, 5, 8100–8107. [Google Scholar] [CrossRef] [PubMed]
- Duran, N.; Marcato, P.D.; Conti, R.D.; Alves, O.L.; Costa, F.T.M.; Brocchi, M. Potential use of silver nanoparticles on pathogenic bacteria, their toxicity and possible mechanisms of action. J. Brazil. Chem. Soc. 2010, 21, 949–959. [Google Scholar] [CrossRef]
- Das, M.R.; Sarma, R.K.; Saikia, R.; Kale, V.S.; Shelke, M.V.; Sengupta, P. Synthesis of silver nanoparticles in an aqueous suspension of graphene oxide sheets and its antimicrobial activity. Colloids Surf. B Biointerfaces 2011, 83, 16–22. [Google Scholar] [CrossRef]
- Khorrami, S.; Abdollahi, Z.; Eshaghi, G.; Khosravi, A.; Bidram, E.; Zarrabi, A. An improved method for fabrication of Ag-GO nanocomposite with controlled anti-cancer and anti-bacterial behavior: A comparative study. Sci. Rep. 2019, 9, 1–10. [Google Scholar]
- Mohamed, M.M.; Ghanem, M.A.; Khairy, M.; Naguib, E.; Alotaibi, N.H. Zinc oxide incorporated carbon nanotubes or graphene oxide nanohybrids for enhanced sonophotocatalytic degradation of methylene blue dye. Appl. Surf. Sci. 2019, 487, 539–549. [Google Scholar] [CrossRef]

| Sample */Bacterial Strain | 0 | 1 | 2 | 3 | 4 |
|---|---|---|---|---|---|
| Streptococcus mutans | 18 | 18 | 18 | 22 | 17 |
| Porphyromonas gingivalis | 14 | 17 | 20 | 19 | 15 |
| Enterococcus faecalis | 14 | 15 | 12 | 17 | 19 |
| Escherichia coli | 14 | 15 | 15 | 18 | 15 |
| Staphylococcus aureus | 14 | 16 | 15 | 18 | 14 |
Publisher’s Note: MDPI stays neutral with regard to jurisdictional claims in published maps and institutional affiliations. |
© 2021 by the authors. Licensee MDPI, Basel, Switzerland. This article is an open access article distributed under the terms and conditions of the Creative Commons Attribution (CC BY) license (https://creativecommons.org/licenses/by/4.0/).
Share and Cite
Prodan, D.; Moldovan, M.; Furtos, G.; Saroși, C.; Filip, M.; Perhaița, I.; Carpa, R.; Popa, M.; Cuc, S.; Varvara, S.; et al. Synthesis and Characterization of Some Graphene Oxide Powders Used as Additives in Hydraulic Mortars. Appl. Sci. 2021, 11, 11330. https://doi.org/10.3390/app112311330
Prodan D, Moldovan M, Furtos G, Saroși C, Filip M, Perhaița I, Carpa R, Popa M, Cuc S, Varvara S, et al. Synthesis and Characterization of Some Graphene Oxide Powders Used as Additives in Hydraulic Mortars. Applied Sciences. 2021; 11(23):11330. https://doi.org/10.3390/app112311330
Chicago/Turabian StyleProdan, Doina, Marioara Moldovan, Gabriel Furtos, Codruța Saroși, Miuța Filip, Ioana Perhaița, Rahela Carpa, Maria Popa, Stanca Cuc, Simona Varvara, and et al. 2021. "Synthesis and Characterization of Some Graphene Oxide Powders Used as Additives in Hydraulic Mortars" Applied Sciences 11, no. 23: 11330. https://doi.org/10.3390/app112311330
APA StyleProdan, D., Moldovan, M., Furtos, G., Saroși, C., Filip, M., Perhaița, I., Carpa, R., Popa, M., Cuc, S., Varvara, S., & Popa, D. (2021). Synthesis and Characterization of Some Graphene Oxide Powders Used as Additives in Hydraulic Mortars. Applied Sciences, 11(23), 11330. https://doi.org/10.3390/app112311330









